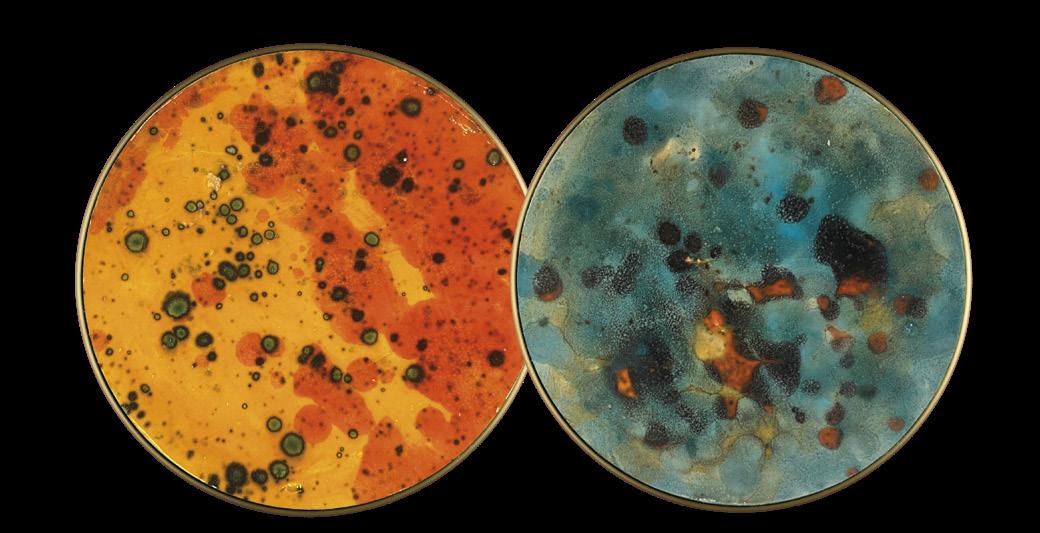

2 minute read
News 2023
from ACB Iluminacion
by ARDENA
Nuestro catálogo general estará disponible para Octubre 2023
Our general catalogue will be ready by October 2023
Advertisement
Notre nouveau catalogue sera prêt pour Octobre 2023
Il nostro catalogo generale sarà pronto entro Ottobre 2023
Unser Gesamtkatalog wird im Oktober 2023 fertig sein







Chamaleon ceramics | cerámica















Chamaleon
THIS WALL LIGHT IS MADE OF 2 PARTS
The gold base with the light source and the disc with differents decorations, both parts are ordered separately.
ESTE APLIQUE SE COMPONE DE 2 PARTES
La base en oro con su fuente de luz y el disco con sus diferentes decoraciones, las dos se piden de forma independiente.
Chamaleon
Made of 100% natural preserved moss. Each disc is made by hand so each item may vary slightly. Moss decorations improve acoustics, help to control room humidity, promote noise reordering, are non-flammable, allergen-free and do not emit CO2. Does not require any care or water. The moss can emanate a woody smell, which disappears after 3-4 weeks and is harmless to health. Indoor use.


Hecho de musgo preservado 100% natural. Cada disco está hecho a mano por lo tanto cada uno puede variar ligeramente. Las decoraciones con musgo, mejoran la acústica, ayudan a controlar la humedad ambiental, favorecen la reordenación del ruido, no son inflamable, están libre de alérgenos y no emiten CO2. No requiere ningún cuidado y ni riego. El musgo puede emanar un olor a madera, que desaparece después de 3-4 semanas y es inofensivo para la salud. Uso en interiores.

1. BASE | BASE
2. DISCS ready to ship | DISCOS listos para enviar
FOR OTHER COLOURS MOQ OF 25 UNITS. CONSULT TO OUR SALES TEAM PARA OTROS COLORES, CANTIDAD MÍNIMA 25 UDS. CONSULTA A NUESTRO EQUIPO COMERCIAL
Chamaleon Chamaleon
ACOUSTIC PANEL | PANEL ACÚSTICO



The acoustic panel is a sustainable product that is made from 60 % recycled PET bottles and 40 % new PET. It significantly improves acoustics, (combined with other acoustic panel variants).
El panel acústico es un producto sostenible que se fabrica con un 60 % de botellas de PET recicladas y un 40 % de PET nuevo. Mejora significativamente la acústica, (combinado con otras variantes de panel acústico).
FOR OTHER COLOURS MOQ OF 25 UNITS. CONSULT TO OUR SALES TEAM PARA OTROS COLORES, CANTIDAD MÍNIMA 25 UDS. CONSULTA A NUESTRO EQUIPO COMERCIAL
Made locally (Manises) Valencia, completely handmade and made to measure. You can combine it with your own decoration, tableware or traditional and/or handmade objects.
As these are handmade products, there may be deviations in colour, texture and thickness. Fabricación local (Manises) Valencia, completamente artesanal y a medida. Puedes combinarlo con tu decoración, vajilla u objetos tradicionales y/o hechos a mano.
Al ser productos artesanales pueden haber desviaciones de color, textura y espesores.
FOR OTHER COLOURS MOQ OF 25 UNITS. CONSULT TO OUR SALES TEAM PARA OTROS COLORES, CANTIDAD MÍNIMA 25 UDS. CONSULTA A NUESTRO EQUIPO COMERCIAL
Chamaleon
Chamaleon
MARBLE | MÁRMOL DECORATION / RAL COLOUR | DECORACIONES / RAL COLOR

COLOURS READY TO SHIP COLORES LISTOS PARA SERVIR
COLOURS READY TO SHIP COLORES LISTOS PARA SERVIR
MATERIAL FINISH SKU METAL METAL MATT ANTIQUE GOLD ORO VIEJO MATE K0003540O

Ø145 2
MATERIAL FINISH SKU
METAL - NATURAL STONE METAL - PIEDRA NATURAL MATT ANTIQUE GOLD - WHITE MARBLE ORO VIEJO MATE - MÁRMOL BLANCO K0003340B

Ø145 ±9
MATERIAL FINISH SKU
METAL - NATURAL STONE
METAL - PIEDRA NATURAL MATT ANTIQUE GOLD - BLACK MARBLE ORO VIEJO MATE MÁRMOL NEGRO K0003340N


Ø145 ±9
MATERIAL FINISH SKU
METAL - NATURAL STONE
METAL - PIEDRA NATURAL MATT ANTIQUE GOLD + GREEN MARBLE ORO VIEJO MATE + MÁRMOL VERDE K0003340VE
Ø145 ±9
MATERIAL FINISH SKU
METAL METAL MATT ANTIQUE GOLD - ROSEWOOD APRICOT ORO VIEJO MATE - ROSA PALO ALBARICOQUE (RAL 20 70 20) K0003040RS
Ø145 2
MATERIAL FINISH SKU
METAL METAL MATT ANTIQUE GOLD - OYSTER WHITE ORO VIEJO MATE - BLANCO PERLA (RAL 1013) K0003040B


Ø145 2
MATERIAL FINISH SKU
METAL METAL MATT ANTIQUE GOLD - JET BLACK ORO VIEJO MATE - NEGRO INTENSO (RAL 9005) K0003040N
Ø145 2 CUSTOM COLOURS PICK ANY DECORATION AND WE DO IT FOR YOU, MOQ 25 UNITS
PRODUCTOS PERSONALIZADOS
SELECCIONA CUALQUIER DECORACIÓN Y TE LO HACEMOS, A PARTIR DE 25 UDS















Doris Doris
















